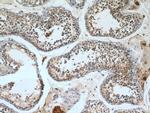
PGK2 Antibody in Immunohistochemistry (Paraffin) (IHC (P))

Search
Proteintech
PGK2 Polyclonal Antibody
{{$productOrderCtrl.translations['antibody.pdp.commerceCard.promotion.promotions']}}
{{$productOrderCtrl.translations['antibody.pdp.commerceCard.promotion.viewpromo']}}
{{$productOrderCtrl.translations['antibody.pdp.commerceCard.promotion.promocode']}}: {{promo.promoCode}} {{promo.promoTitle}} {{promo.promoDescription}}. {{$productOrderCtrl.translations['antibody.pdp.commerceCard.promotion.learnmore']}}
产品信息
13686-1-AP
种属反应
已发表种属
宿主/亚型
分类
类型
抗原
偶联物
形式
浓度
规格
纯化类型
保存液
内含物
保存条件
运输条件
产品详细信息
Immunogen sequence: YTFLKVLNN MEIGASLFDE EGAKIVKDIM AKAQKNGVRI TFPVDFVTGD KFDENAQVGK ATVASGISPG WMGLDCGPES NKNHAQVVAQ ARLIVWNGPL GVFEWDAFAK GTKALMDEIV (242-360 aa encoded by BC038843)
靶标信息
PGK2 is a form of phosphoglycerate kinase unique to spermatozoa. The autosomal PGK2 gene lacks introns and contains characteristics of a processed gene. The conservation of function in this processed PGK2 gene and its tissue-specific expression in spermatogenesis suggests that it exists as a compensatory response to the inactivation of the X-linked PGK1 gene in spermatogenic cells before meiosis.
仅用于科研。不用于诊断过程。未经明确授权不得转售。
生物信息学
蛋白别名: epididymis secretory protein Li 272; Phosphoglycerate kinase 2; phosphoglycerate kinase autosomal pseudogene; Phosphoglycerate kinase, testis specific; testicular tissue protein Li 139; unnamed protein product
基因别名: dJ417L20.2; HEL-S-272; Pgk-2; PGK2; PGKB; PGKPS; Tcp-2
UniProt ID: (Human) P07205, (Mouse) P09041
Entrez Gene ID: (Human) 5232, (Rat) 316265, (Mouse) 18663